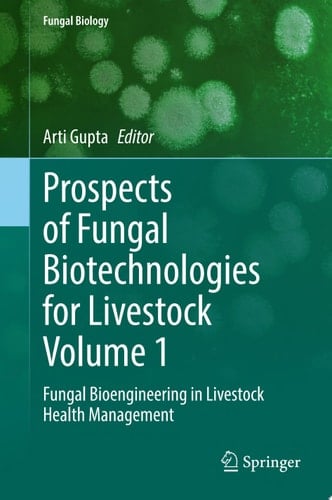
Prospects of Fungal Biotechnologies for Livestock Volume 1

This multi-volume set covers a great amount of research done on fungal infection, emphasizing relevant data in the discussion. It is intended to address the major causes of fungal biotechnological aspects while bringing in the most recent data concerning discoveries in livestock management. Each volume in the set will give readers the necessary information, complemented by areas of focus of the accompanying volumes. The set covers topics spanning from basic concepts to health management to engineering using cell lines and approaching bioprocess technology, with a particular focus on recent developments. Volume 1 discusses the different ways in which fungal biotechnologies can be used to improve livestock health, including through the use of probiotics and biocontrol agents. How assisted reproduction technologies have played a crucial role in enhancing livestock production from a domestic practice to a commercial enterprise is addressed in this publication.The book also delves into the current therapy applied to deal with fungal infections, as well as innovations in the livestock field. Lastly this book touches upon the potential economic benefits that these biotechnologies can bring to farmers and stakeholders.
Page Count:
256
Publication Date:
2025-07-23
No comments yet. Be the first to share your thoughts!